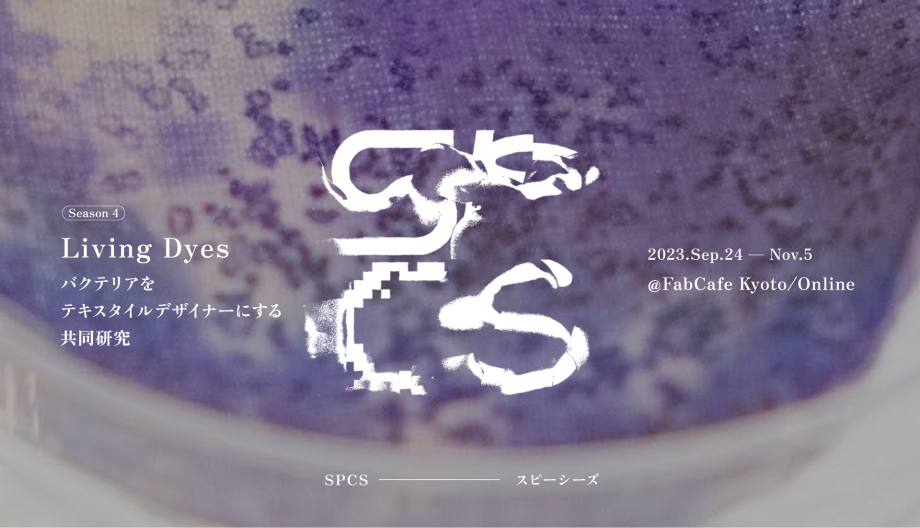

Exhibition
- #開催終了
- #入場無料

生きた色のあるバクテリアを繊維の上で培養することで染色するバクテリア染色。日本ではまだ取り組みの少ないこの染色方法を1.5カ月にわたって多様なメンバーと実施しました。その研究結果や実際に染色した作品を展示します。ぜひこの機会にお越しください。また、企画者より作品を直接ご説明することも可能です。
2023.11.30 (木) – 2023.12.6 (水) UTC+09:00
10:00 – 20:00 展示はお店の営業時間と一致します
FabCafe Tokyo | Google mapで開く
観覧無料 *カフェの席を利用する場合はワンドリンクのご注文をお願いいたします。
観覧のみは予約必要ありません。展示案内希望の方、申し込みお願いいたします
生きているバクテリアをテキスタイルデザイナーとして共創する共同実験の成果展示
生きた色のあるバクテリアを繊維の上で培養することで染色するバクテリア染色。日本ではまだ取り組みの少ないこの染色方法を1.5カ月にわたって多様なメンバーと実施しました。その研究結果や実際に染色した作品を展示します。
今回は、紫色の色素を持つJanthinobacterium lividumを用いて、染色家、アーティスト、デザイナーなど、さまざまな領域のメンバーがバクテリアの培養と染色を行いました。コントロールしようとしすぎない、不安定さや操作できないからこそできる表現は何か、また、本当にバクテリア染色が環境負荷染が低い技術として可能性がありそうなのか、さまざまなアングルから実験が行われました。
なお、企画者より作品を直接ご説明することも可能です。ご案内希望の方は申し込みフォームを記入してください。
お問い合わせ
SPCS事務局(浦野奈美、サラ・ホー)
spcs@loftwork.com
https://www.instagram.com/spcs_fabcafekyoto/
-

赤いバクテリアで染めた絹を紡いだ糸(坂入幸子さん)
-

作品「邪魔したり、誘導したり、真似したり」(水田薫さん)は、さまざまな障害物を作ることでバクテリアの増殖パターンに「邪魔」をして、さまざまな模様を作り出した作品群
-

青栁徹さんは、活動拠点である栃木県で採掘される軽石凝灰岩の石材、大谷石を染色した
-

「蚕がバクテリアを食べたらバクテリアの色の糸を吐くだろうか」という問いから始まった、Hiroki Kaimotoさんの研究
-
ファッション産業は、世界で最も環境汚染が指摘されている産業のひとつです。しかし、PUMAやLVMHなどのアトリエやラボでの最先端の研究により、生きているバクテリアが染色工程をよりクリーンに解決できるという可能性が示されました。そこで、バイオアーティストのゲオアグ・トレメルを講師に、また、バクテリア染色に長年取り組んでいるテキスタイルデザイナーのジュリア・モーザーをオブザーバーとして招き、テキスタイルの生産に微生物と共創する実験を実施しました。
-
オーストリアを拠点に活動するテキスタイル/ファッションデザイナーのジュリア・モーザーさんのインタビュー。彼女が取り組むバクテリア染色の背景にある動機や、バクテリア染色がファッションと製造業界にもたらす意味と可能性について話を聞きました。
マイクロバイオーム、放射線、ウィルス、細菌。コントロールできない自然の力は、厄介者やエラーと扱われることも多く、多くの排除や操作がおこなわれてきました。しかし、人間が操作できない生物のパワーをいかにポジティブに捉え直し、遊び、クリエイティブに生かす器をデザインできるかが、これからの活動のポイントとなってくるでしょう。
SPCS(スピーシーズ)は、プロトタイピングしながら自然のアンコントローラビリティを探究する活動体です。自身の好奇心や課題感と自然のメカニズムをリンク・身体化させ、価値観や手法をアップデートさせるべく、領域横断の実験を行っています。
活動全体のコンセプト/過去の活動は こちら>>
-
Georg Tremmel
アーティスト、BioClub Tokyoディレクター、東京芸術大学客員教授
オーストリア出身のアーティストで、東京を拠点に活動。ウィーンとロンドンで生物学、情報学、メディアアートを学ぶ。2001年より、生物学、文化、倫理、社会の規範をテーマに、アーティスティック・リサーチ・フレームワークBCLを福原志保とともに結成。議論可能なオブジェ、インスタレーション、シチュエーションを制作している。
現在、ウィーン応用芸術大学の博士課程に在籍し、「Ludic Cultures, Biologial Interfaces and Non-Human Agencies」をテーマに研究している。また、早稲田大学岩崎秀雄研究室の生命をめぐる科学・思想・芸術に関わる表現・研究のプラットフォーム「metaPhorest」の客員研究員、東京藝術大学の客員教授でもある。
日本初のオープン・バイオラボ&バイオハッカースペースであるBioClub Tokyoの共同設立者であり、ディレクターを務めている。オーストリア出身のアーティストで、東京を拠点に活動。ウィーンとロンドンで生物学、情報学、メディアアートを学ぶ。2001年より、生物学、文化、倫理、社会の規範をテーマに、アーティスティック・リサーチ・フレームワークBCLを福原志保とともに結成。議論可能なオブジェ、インスタレーション、シチュエーションを制作している。
現在、ウィーン応用芸術大学の博士課程に在籍し、「Ludic Cultures, Biologial Interfaces and Non-Human Agencies」をテーマに研究している。また、早稲田大学岩崎秀雄研究室の生命をめぐる科学・思想・芸術に関わる表現・研究のプラットフォーム「metaPhorest」の客員研究員、東京藝術大学の客員教授でもある。
日本初のオープン・バイオラボ&バイオハッカースペースであるBioClub Tokyoの共同設立者であり、ディレクターを務めている。 -
Julia Moser
テキスタイル&ファッションデザイナー/Growing Patterns Living Pigments創設
ジュリア・モーザーは、ファッションやテキスタイルのデザイン手法や生産プロセスを、より持続可能で健康的な未来に向けて再考することを自分の使命だと考えている。化学物質や有害な成分を使わずに色を作り出す方法を自然が知っているという事実を受け、「Growing Patterns Living Pigments」を設立。テキスタイルを染めるため、顔料生成バクテリアとの共創を始め、デザインプロセスにも彼らを巻き込んでいる。マテリアルイノベーションとバイオデザインに焦点を当て、新しいテクノロジーを使うことでデザインやデザインプロセスの考え方を変える方法を模索している。
先住民族であるコギ族の「テクノロジーを使って仕事をするのは当然だが、そうするならば、自然に逆らわず、自然と共に働くテクノロジーを使いなさい」という言葉を常に心に留めている。リンツ芸術デザイン大学でテキスタイル・アート・デザインとファッション・テクノロジーの2つの修士号を取得。現在はCrafting Futures Labで大学アシスタントとして勤務しながら博士号を取得、学生を指導している。デザイン実践のためのコアバリューを見つけ、素材との接続方法をデザインすることで、芸術と科学、伝統と新しい技術の間に橋をかけ、自然とのつながりを取り戻し、次の世代のための未来を創造している。
ジュリア・モーザーは、ファッションやテキスタイルのデザイン手法や生産プロセスを、より持続可能で健康的な未来に向けて再考することを自分の使命だと考えている。化学物質や有害な成分を使わずに色を作り出す方法を自然が知っているという事実を受け、「Growing Patterns Living Pigments」を設立。テキスタイルを染めるため、顔料生成バクテリアとの共創を始め、デザインプロセスにも彼らを巻き込んでいる。マテリアルイノベーションとバイオデザインに焦点を当て、新しいテクノロジーを使うことでデザインやデザインプロセスの考え方を変える方法を模索している。
先住民族であるコギ族の「テクノロジーを使って仕事をするのは当然だが、そうするならば、自然に逆らわず、自然と共に働くテクノロジーを使いなさい」という言葉を常に心に留めている。リンツ芸術デザイン大学でテキスタイル・アート・デザインとファッション・テクノロジーの2つの修士号を取得。現在はCrafting Futures Labで大学アシスタントとして勤務しながら博士号を取得、学生を指導している。デザイン実践のためのコアバリューを見つけ、素材との接続方法をデザインすることで、芸術と科学、伝統と新しい技術の間に橋をかけ、自然とのつながりを取り戻し、次の世代のための未来を創造している。
主催
-
FabCafe Kyoto
-
Loftwork Kyoto
-
日時
-
2023.11.30 (木) – 2023.12.6 (水) 10:00 – 20:00 展示はお店の営業時間と一致します UTC+09:00
-
会場
-
FabCafe Tokyo
東京都渋谷区道玄坂1-22-7 道玄坂ピア1F
京王井の頭線 神泉駅 南口 徒歩3分
JR 渋谷駅 徒歩10分
03-6416-9190
Google mapで開く -
参加費
-
観覧無料 *カフェの席を利用する場合はワンドリンクのご注文をお願いいたします。
-
オーガナイザー
-
主催: FabCafe Kyoto, Loftwork Kyoto
観覧のみは予約必要ありません。展示案内希望の方、申し込みお願いいたします